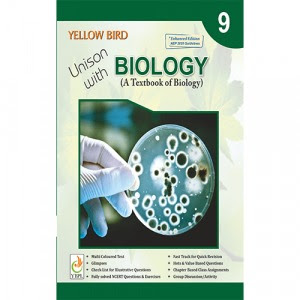

Biology Class 10 Book by Yellow Bird Publications: A Comprehensive Guide for Students

When it comes to preparing for Class 10 exams, a well-structured and reliable textbook plays a crucial role in ensuring that students understand key concepts effectively. The Biology Class 10 Book by Yellow Bird Publications is designed to be a comprehensive and user-friendly resource that simplifies complex biological concepts, making them easier to grasp for students. This book covers the entire Class 10 Biology syllabus prescribed by most educational boards, including CBSE, ICSE, and various state boards. With clear explanations, engaging illustrations, and a structured approach, it serves as an ideal study companion for students aiming to excel in their biology exams. Key Features of the Biology Class 10 Book: Comprehensive Coverage : The book includes all the essential topics from the Biology Class 10 Book curriculum, such as cell structure, human physiology, genetics, evolution, and ecology. It is divided into chapters that are aligned with the official syllabus, ensuring that...